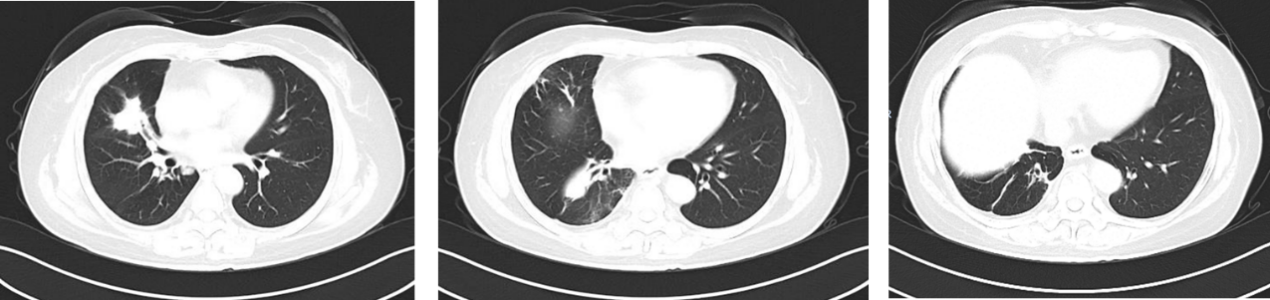

近年,靶向与免疫治疗并驾齐驱,已将晚期非小细胞肺癌(NSCLC)推入“长生存”时代。然而,靶点稀缺、免疫治疗相关不良反应频发,仍令不少患者的治疗之路陡然“卡关”,临床决策进退维谷。节拍化疗(MCT)这一新兴策略,通过低剂量、高频次给药持续抑制肿瘤,为临床提供了一种安全、有效的治疗选择。其中,口服长春瑞滨节拍化疗已在肺癌、乳腺癌、前列腺癌等多种实体瘤中取得了良好疗效[1]。本次病例聚焦于一位TP53突变肺腺癌患者。该患者一线接受免疫联合化疗虽获 PR,却因血液学毒性等不良反应被迫停用化疗;续行免疫单药再遭免疫治疗相关性糖尿病,二线白蛋白紫杉醇两周期即病情进展(PD),且患者拒绝静脉化疗。三线改用口服长春瑞滨节拍化疗,影像评估重返 PR,且患者耐受性良好,至2025年4月随访已维持超过9个月的稳定控制。
特邀嘉宾
病例分享专家
医学硕士、腹盆腔肿瘤科
毕业于天津中医药大学七年制中医肿瘤专业,师承天津中医药大学研究生院院长、心血管专家徐宗佩教授,天津市人民医院肿瘤科专家姚嫱主任,拜师全国名老中医花宝金教授,黄元御医学流派第八代传承人。
基于肿瘤疾病的特殊性,临证重视“肝-脾胃系统”在肿瘤发生及预后方面的重要性,在肿瘤癌前病变防治方面有诸多研究总结,临床擅长妇科肿瘤的中西医结合综合治疗;肿瘤放化疗后副反应、肿瘤并发症(癌性疼痛、厌食、乏力、胸腹腔积液等)的中医药调理;擅长中药内服外治治疗结节类疾病(包括甲状腺结节、肺结节、乳腺结节等);常见消化系统疾病、心脑血管疾病、妇科良性疾病(乳腺增生、子宫肌瘤、卵巢囊肿、月经不调等)、男科常见疾病(阳痿、早泄)的中医药调理。
任职于沧州市抗癌协会传统医学专业委员会秘书,河北省中西医结合学会热疗专业委员会常委,河北省中医院学会肿瘤专业委员会常委,沧州市中医药协会肿瘤专业委员会常委,中国中医药信息研究会青年医师分会理事,中国中医药促进会委员等。
病例点评专家
河北省沧州中西医结合医院腹盆腔肿瘤科
中国抗癌协会肿瘤热疗专业委员会河北省分会委员
河北省中西医结合学会肿瘤热疗专业委员会常务委员
河北省女医师协会肿瘤微创介入专业委员会常务委员
河北省急救医学会放射肿瘤治疗专业委员会常务委员
河北省女医师协会放射肿瘤专业委员会委员
河北省抗癌协会近距离放射治疗专业委员会委员
病例介绍
患者:女,58岁。
主诉:咳嗽、咳痰、间断发热3月余。
现病史:2022年11月,患者无明显诱因出现咳嗽、咳痰、间断发热。查体:神清,精神可,周身浅表淋巴结未触及肿大,双肺呼吸音粗,右肺呼吸音稍减低,未闻及明显干湿性啰音,心率76次/分,律齐,未闻及明显病理性杂音,腹软,无压痛、反跳痛及肌紧张,双下肢无水肿。PS=1分。
2023年2月,查胸部增强CT(图1)示:右肺下叶病变,伴部分肺实变,右侧肺门及纵膈内多发增大淋巴结,双肺多发磨玻璃结节。全身骨ECT(2022-03-03,图2)示:左6前肋骨代谢增高;T5、L5椎体骨代谢增高,结合病史提示骨转移。腹部CT、头颅MRI未见明显转移。


既往史及个人史:既往体健,无遗传病等家族史。否认吸烟史。
辅助检查:
CT引导下经皮肺穿刺活检:(右肺下叶)非小细胞肺癌,结合免疫表型符合腺癌。免疫组化:CK5/6(-),CK7(+),Ki67(30%),NapsinA(+),P40(-),P63(-),TTF-1(+),PD-L1<1%。
EBUS:(7组、11R组淋巴结):少许异形细胞团,结合免疫表型结果,符合肺腺癌浸润/转移。免疫组化:1号切片:CK5/6(-),CK7(+),Ki67(3%),NapsinA(-),P40(-),P63(-),TTF-1(+); 2号切片:CK5/6(-),CK7(+),Ki67(3%),NapsinA(+),P40(-),TTF-1(+)。
基因检测:TP53突变(丰度 10.4%)。
临床诊断:右肺腺癌(c-T2N2M1, PS 1分)伴骨转移
治疗过程:
一线治疗:
2023年3月-2023年8月,行6周期“培美曲塞0.8g+卡铂600mg+信迪利单抗 200mg”方案治疗,并行骨转移灶局部放疗:30Gy/10F。
最佳疗效评估:PR。
2023年8月-2024年3月,行信迪利单抗免疫治疗。
2024年5月,复查CT,评估为SD,但病灶略有增大。



不良反应:第一次全身治疗后1周,患者因“胸闷、气短2天”再次入院。【实验室检查】血氧饱和度:90%;血气分析:PO2 72.80 mmHg PCO2 42.40 mmHg;凝血功能:D-二聚体 3.93 mg/L;BNP及心梗三项正常范围。【双下肢彩超】:双下肢动脉所显示段粥样硬化,附壁斑块,左下肢深静脉血栓。【影像学检查】:肺动脉CTA:肺动脉干分叉处、左右肺动脉及其部分分支多发栓塞形成。考虑尚无血流动力学改变,且为中低危患者,口服利伐沙班片抗凝治疗。

第3周期治疗后出现Ⅲ度中性粒细胞下降及Ⅰ度血小板下降,免疫检查点抑制剂相关基线检测未见明显异常,后期应用聚乙二醇化重组人粒细胞刺激因子(PEG-rhG-CSF) Ⅱ级预防及其他对症治疗。
2024年5月,患者末次免疫治疗后1周,因“头晕、恶心、胸闷、气短3天”急诊入院。【实验室检查】血糖:38.9mmol/L,血钾:6.7mmol/L,乳酸:6.5mmol/L,尿酮体:(3+),糖化血红蛋白:7.4%。【影像学检查】头颅MRI未见脑转移征象。考虑为免疫治疗相关性糖尿病,予以重组甘精胰岛素及甘舒霖R控制血糖、降钾、补液治疗后,患者后期空腹血糖控制在6-8mmol/L。二次活检示:驱动基因阴性。
二线治疗:
2024年5月-2024年6月,行2周期白蛋白紫杉醇治疗。
疗效评估:PD。
三线治疗:
2024年7月至2025年4月,行长春瑞滨软胶囊(40mg,每周一、三、五)口服治疗。
疗效评估:PR。


病程小结

病例点评
张永侠教授:本病例为一位初诊58岁女性患者,因“咳嗽、咳痰、间断发热3月余”就诊。该患者在治疗过程中多次出现不良反应,后因患者拒绝静脉化疗,三线调整为口服长春瑞滨节拍化疗,不仅耐受良好,且疗效达到PR,成功实现“疗效-生存-生活质量”的三重突围,为“靶向不可及、免疫不耐受”的难治性 NSCLC 提供了可及、可耐受、可复制的长效新选择。
诊断方面,患者查胸部增强CT提示右肺下叶病变;全身骨ECT显示骨代谢增高,提示骨转移;腹部CT、头颅MRI未见明显转移。CT引导下经皮肺穿刺活检、超声支气管镜明确为肺腺癌,最终确诊为右肺腺癌(c-T2N2M1),基因检测提示TP53突变。
治疗方面,TP53是NSCLC中最常见的突变基因之一,与NSCLC预后较差有关[2]。然而,本例却未见可靶向共突变,免疫联合化疗成为此类患者一线首选。ORIENT-11研究显示,在局部晚期或转移性NSCLC中,与单纯化疗相比,信迪利单抗联合培美曲塞和铂类化疗一线治疗可将中位总生存期(OS)从16.8个月延长至24.2个月(HR=0.65;95% CI 0.50-0.85)[3]。遂本例患者一线给予信迪利单抗联合化疗,并针对骨转移行局部放疗,疗效达到PR。但患者在治疗期间出现中性粒细胞、血小板下降等不良反应,不得不停用化疗,仅使用信迪利单抗单药免疫治疗。然而,末次免疫治疗后,患者再次出现头晕、恶心、胸闷、气短等症状,完善检验检查,考虑为免疫治疗相关性糖尿病。在免疫治疗不可用的情况下,化疗成为临床最后一道防线,故二线采用白蛋白紫杉醇治疗,但治疗2周期后,患者病情再次进展,且不愿再行静脉化疗,后续治疗该如何选择?
2000年被首次提出的MCT概念,是一种以肿瘤组织内增殖的血管内皮细胞和基质细胞为靶点,通过抗肿瘤血管生成、调节免疫细胞功能、调节肿瘤干细胞和肿瘤细胞休眠等多种机制抑制肿瘤生长,同时减少不良反应的发生,延缓肿瘤复发和耐药的新型治疗模式[1,4]。长春瑞滨是MCT最理想的药物[5]。作为一种半合成的长春生物碱,长春瑞滨主要通过抑制微管蛋白的解聚和纺锤体的形成而发挥抗肿瘤作用[4]。其口服剂型不仅拥有静脉制剂相当的疗效,药代动力学稳定,不受饮食、年龄、人种等因素的影响,长期使用无累积毒性,耐受性良好而且服用方便,能够避免静脉导管炎等静脉用药风险,减少对日常生活的干扰,患者用药依从性高,也更适于高频次的长期用药 [1,6-11]。
多项研究已经证实长春瑞滨节拍化疗在肺癌中的疗效及安全性[1,3,4,7,11]。CAMERINIA等回顾性分析了270例Ⅲ-Ⅳ期NSCLC患者口服长春瑞滨单药节拍化疗一线、二线、三线的治疗疗效,总体缓解率达17.8%,其中46例患者达到PR,病情稳定超过12周的患者有119例,总体疾病控制率(DCR)达61.9%,中位OS为9个月,仅2%的患者发生3-4级不良反应,主要为疲劳和贫血[1]。MOVE研究结果亦提示,即便在老年晚期NSCLC患者中,口服长春瑞滨节拍化疗一线治疗的总体临床获益率(CBR)仍达58.1%,中位PFS为5个月,中位OS为9个月,且安全性良好,严重毒性反应罕见[7]。
基于上述证据并尊重患者意愿,本例患者三线采用口服长春瑞滨节拍化疗,疗效评估达到PR。截至末次随访时间(2025年4月),患者连续用药9个月余,无明显不良反应,疾病控制稳定,初步实现晚期肺癌的长期慢病化管理。
[1]李易泽,张立,杨宏平,等.长春瑞滨节拍化疗在晚期非小细胞肺癌患者中的应用[J].现代肿瘤医学,2022,30(18):3400-3403.
[2]Matthew Kin Liang Chiu, et al. Exploring the prognostic value of TP53 mutation in NSCLC in the era of precision oncology: A prospective real-world study. 2024 ELCC Abstract #51P; Annals of Oncology (2024) 9 (suppl_3): 1-53. 10.1016/esmoop/esmoop102569。
[3]Final overall survival (OS) data of sintilimab plus pemetrexed (SPP) and platinum as fifirst-line (1L) treatment for locally advanced or metastatic nonsquamous NSCLC (AMnsqNSCLC) in the phase III ORIENT-11 study.2022 ELCC,abs 4MO.
[4]刘花,陈延绅,尤慧柠,等.长春瑞滨节拍化疗的药动学及药理学作用机制研究进展[J].中国临床药学杂志,2022,31(01):71-76.DOI:10.19577/j.1007-4406.2022.01.016.
[5]祝情情,谢超,宋宝,等.节拍化疗在晚期非小细胞肺癌治疗中的应用[J].国际肿瘤学杂志, 2019, 46(6):4.DOI:10.3760/cma.j.issn.1673-422X.2019.06.013.
[6] Yunpeng Yang, Jianhua Chang, Cheng Huang, et al. A randomised, multicentre open-label phase II study to evaluate the efficacy, tolerability and pharmacokinetics of oral vinorelbine plus cisplatin versus intravenous vinorelbine plus cisplatin in Chinese patients with chemotherapy-naive unresectable or metastatic non-small cell lung cancer[J]. J Thorac Dis. 2019 Aug;11(8):3347-3359.doi: 10.21037/jtd.2019.08.22.
[7]Andrea Camerini , Cheti Puccetti , Sara Donati ,et al. Metronomic oral vinorelbine as first-line treatment in elderly patients with advanced non-small cell lung cancer: results of a phase II trial (MOVE trial).BMC Cancer . 2015 May 6;15:359.
[8]Dolores Isla, Ramón De Las Peñas, Amelia Insa, et al. Oral vinorelbine versus etoposide with cisplatin and chemo-radiation as treatment in patients with stage III non-small cell lung cancer: A randomized phase II (RENO study). Lung Cancer. 2019 Sep:135:161-168. doi: 10.1016/j.lungcan.2018.11.041. Epub 2018 Dec 1.
[9] P Katsaounis, A Kotsakis, S Agelaki, et al. Cisplatin in combination with metronomic vinorelbine as front-line treatment in advanced non-small cell lung cancer: a multicenter phase II study of the Hellenic Oncology Research Group (HORG)[J]. Cancer Chemother Pharmacol. 2015 Apr;75(4):821-7.
[10]刘花,陈延绅,尤慧柠,等.长春瑞滨药动学及毒副作用研究进展[J].中国药房,2022,33(11):1403-1408.
[11]林金兰, 郭天兴, 潘小杰, 徐振武. 长春瑞滨软胶囊单药节拍化疗一线治疗老年非小细胞肺癌临床疗效观察[J]. 肿瘤防治研究, 2018, 45(11):909-912.
排版编辑:肿瘤资讯-黄洋洋






苏公网安备32059002004080号